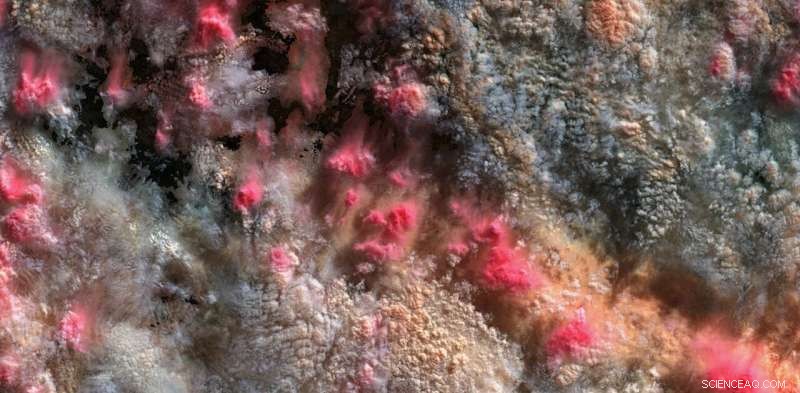
Revolutionizing Climate Science: How Rejected Satellite Data Unveils New Cloud Insights

Credit: Grayson Cooke, Author provided
Clouds have been objects of reverie and wonder throughout human history, inspiring art and imagination, and of course warning of extreme weather events.
Clouds are also central players in Earth's climate. They move water around the globe, reflect sunlight and interact with radiation emitted by the Earth, and in so doing can both cool and warm the planet.
How clouds react as the planet heats up is a matter of serious concern. As the latest Intergovernmental Panel on Climate Change (IPCC) report reiterates, we sit on the brink of a precipice in terms of our ability to slow or halt the global heating humans are causing.
Climate scientists study clouds closely, but translating scientific findings into forms that catch the public imagination is not always an easy task. Our new film, Path 99, uses satellite imagery and the tools of art and science to show clouds in a spectacular new light.
Satellites, clouds and invalid data
Remote sensing satellite data is produced by a very large multinational effort, and it makes an immense contribution to our knowledge of the world. Meteorology, geoscience and climate science all rely on satellite data.
But we can gain even more from this data if we explore it via the creative arts. When we bring knowledge to life through imagination and feeling, we can create new ways of experiencing, understanding and responding to our planet.
Path 99—which launches next week at the New Zealand International Film Festival—uses satellite images of clouds over Australia to highlight the importance of clouds to climate. Designed to be viewed on the domed screen of a planetarium with an enveloping electronic soundtrack, it combines art, science and Earth.
We used data from two satellites, America's Landsat 8 and Japan's Himawari 8, made available by Geoscience Australia and the Digital Earth Australia program, and the Bureau of Meteorology.
Landsat 8 is an Earth observation satellite mainly used for monitoring environmental conditions at ground level. Its orbit takes it over the poles while the planet spins beneath it, which means it can view the entire globe over the course of a 16-day cycle of 233 orbits or "paths." The track running down the center of Australia is path 99, hence the film's title.
For geoscientists, clouds are an obstruction to the view of the land from orbit. They use software to comb through satellite data pixel by pixel, identifying and removing clouds and other atmospheric noise to obtain clear images.
At any given time, clouds cover around two-thirds of Earth, so what the scientists sift out creates a vast archive of "invalid data"—a multi-year record of incredible cloud formations.

'Invalid Data: Kati Thanda / Lake Eyre 12/03/2017' (2019). This Landsat 8 satellite image shows clouds over Kati Thanda / Lake Eyre on March 12 2017. Credit: Grayson Cooke, NASA/USGS Landsat 8 OLI
Our project focuses on this "invalid data," showing the clouds, cloud shadow and gauzy fragments of land that are deemed unusable for scientific Earth observation.
A scientist's waste can be an artist's treasure. Projects like ours, combining art and science, show what can be gained when we look at the aesthetic qualities of the objects of scientific enquiry from a more human-centered perspective.
Clouds in a new light
Landsat 8's sensor records what is known as "multi-spectral" imagery. This is data recorded in "bands" that isolate specific parts of the electromagnetic spectrum, from visible light to the near infrared.
Scientists use the infrared bands to study plants and water. When we used them to render clouds, we discovered startling colors, textures and forms.
The dramatic shift in colouration that results from mapping the infrared bands into the visible spectrum, turning shades of white and gray into highly colored tableaux, translates clouds into something radically unexpected.
Scientifically speaking, the colored images reveal the remarkable spectral complexity of clouds, in terms of which wavelengths of sunlight they reflect and which they absorb. The variations in color reflect wide ranges of cloud temperatures, densities, and heights, as well as the presence or absence of dust and other aerosol particles.

On the right is a ‘true colour’ image, mapping the red, green and blue bands (432) of the sensor to RGB in the output image. On the left is a ‘false colour’ image, mapping the near infrared, and two shortwave infrared bands (567) of the sensor to RGB. The infrared image picks out large variation in cloud structure and therefore height, temperature and opacity more effectively than the true colour image. Credit: Grayson Cooke, NASA/USGS Landsat 8 OLI.
Tracing vapor
The Himawari 8 satellite sits in a geostationary orbit high above a point on the equator just north of Papua New Guinea. Its field of view allows it to record multi-spectral images of much of the Asia-Pacific region every 10 minutes, including several infrared bands used to track gases and other particles in the atmosphere.
In the video clips shown in this article, Path 99 uses bands designed to show the transport of water vapor around the planet. This allows us to see Australia's clouds in their wider context, as part of the massive circulations that distribute thermal energy around the Earth.
Heads in the clouds
As modern human existence increasingly transforms the Earth, its atmosphere and climate, we need new ways to understand, represent and address this impact.
Cloud behaviors are vital clues to the extent of the changes in climate and weather. Now more than ever, we should all have our heads in the clouds.